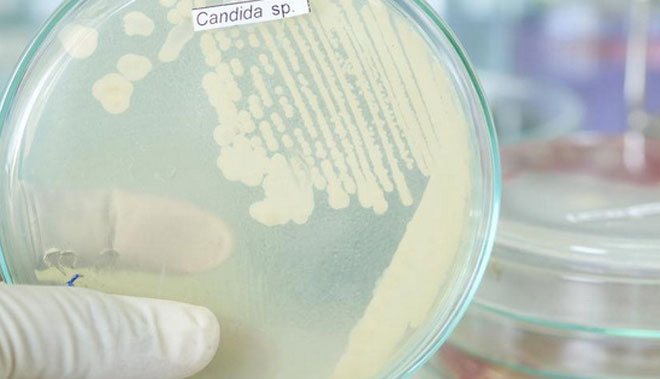
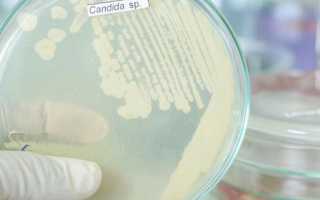

Такое грибковое заболевание, как молочница, или в медицине кандидоз, — достаточно частая инфекция. Зачастую недуг поражает женщин, но бывают случаи, когда заболевают мужчины, а в довольно редких случаях и дети. Грибки типа Candida можно найти в организме любого человека, однако заболевание может проявиться лишь под влиянием некоторых причин, которые ослабляют защитные функции. Во время инкубационного периода молочницы происходят изменения в организме, при которых инфекция укрепляется в микрофлоре инфицированного.
Как быстро происходит инфицирование
Длительность инкубационного периода молочницы (то есть от заражения до появления первых признаков) — от 2 дней до 2 месяцев. Частные случаи изменения инкубационного периода при молочнице:
- от 3 недель до 2 месяцев — при развитии кандидозного утретрита;
- от 2 дней до 2 недель — при развитии кандидозного баланита или вульвовагинита.
Лечение заболевания
Кандидоз не представляет серьезной опасности для организма пациента, однако, сопровождается массой неприятных ощущений. Устранение молочницы проходит в несколько этапов:
- Подавляющее воздействие на рост болезнетворных грибов;
- Нормализация состояния микрофлоры влагалища;
- Повышение защитных функций организма.
Лечение молочницы проводится с помощью:
- Дифлюкана;
- Гинезола;
- Низоала.
Эти лекарственные препараты принимаются внутрь либо назначаются в виде кремов и свечей. То или иное лекарственное средство, его дозировка и режим приема определяется только лечащим врачом с учетом формы заболевания и тяжести.
Во время лечения кандидоза требуется отказаться от ведения половой жизни на несколько недель. Рекомендуется подвергнуть лечебной терапии и второго полового партнера независимо от того, присутствуют ли у него симптомы заболевания.
Это связано с тем, что присутствует опасность того, что возможен переход заболевания от одного полового партнера к другому. После лечения с применением антибактериальных препаратов проводится восстановление микрофлоры влагалища. Для этих целей используют такие препараты, как:
- Ацилакт
- Бифидумбактерин.
Кроме этого, молочница нуждается в обязательном соблюдении правил личной гигиены, что позволяет ускорить процесс выздоровления.
Кандидоз является неприятным заболеванием, которое может доставить массу дискомфорта и неприятных ощущений. Пациентам необходимо знать, на какой день обычно проявляется молочница, что позволит диагностировать патологию как можно раньше. Отсутствие ранее беспокоивших симптомов кандидоза совершенно не обозначает, что заболевание полностью излечилось. Именно по этой причине после проведения медикаментозной терапии важно посетить специалиста, который подтвердит эффективность лечения.
Как развивается кандидоз
Развитие молочницы у каждого человека происходит по-разному.
- Скрытое формирование патологии при ее латентной форме происходит в течение 3 — 5 дней. Если же кандидоз осложнен вульвовагинитом, то первые симптомы патологии проявляются только через две недели после заражения.
- Иногда заболевание может проявляться только через 2 месяца после инфицирования. Это бывает, когда человек болеет уретритом с поражением мочеиспускательного канала.
- Молочница у мужчин проявляется в период от нескольких дней до нескольких месяцев.
О симптомах
В случае обнаружения кандидоза у мужчин или женщин следует сразу же приступать к лечению. Таким образом удастся исключить переход болезни в хроническую форму. Всем людям нужно взять на заметку следующие признаки проявления кандидоза:
- Спустя день или несколько суток после полового акта болезнь проявляется в форме болезненных ощущений во время мочеиспускания.
- Иногда симптомы проявляются в виде характерного жжения и зуда в области половых органов.
- Нередко наблюдаются характерные выделения белого цвета во влагалище.
- Во рту возможно появление язвочек с белым налетом.
- На кожном покрове нередко возникает сыпь.
Указанные симптомы будут говорить о том, что произошло инфицирование, которое спровоцировало развитие грибка в организме. Иными словами, скрытая форма болезни перешла в острую. Проявления молочницы часто схожи с теми, которые возникают по причине воспаления мочевого пузыря, придатков и яичников. Иногда зараженные люди страдают от ноющей боли в области спины. Часто такие симптомы указывают на возникновение остеохондроза, невралгии.
У женщин молочница часто появляется перед началом менструации. Кандидоз проявляется наличием зуда, боли в районе расположения яичников, обильных или, наоборот, скудных выделений. Имейте в виду, что молочница чаще всего возникает у женщин, страдающих аллергическими заболеваниями.
После прохождения курса лечения у женщины кандидоз может снова возникнуть. Это объясняется тем, что носителем заболевания является партнер. Пока пара совместно не пройдет курс лечения, от болезни избавиться не получится. После нового полового контакта придется снова начинать восстанавливать здоровье.
Поэтапное формирование молочницы
Кандидоз проходит в своем формировании несколько этапов.
- Проникновение возбудителя патологии. Обычно это происходит во время полового контакта. Реже возбудитель болезни попадает с какого-либо инфицированного участка на слизистую оболочку. Закрепление патогенного агента происходит только в том случае, если иммунная система работает с большими нарушениями.
- Размножение возбудителя. Количество грибка быстро увеличивается. На этом этапе наблюдаются первые видимые симптомы болезни.
- Прогрессирование. Кандиды проникают в ткань на глубину примерно 7 мм. Происходит усиление проявления патологии. Если ее не лечить, то она быстро перейдет в хроническую форму.
- Попадание болезнетворного агента в кровь. Грибки поражают организм человека на фоне инфицирования органов. Патология способна распространяться в легкие, почки. Это особенно опасно во время беременности: молочница способна нанести огромный вред развивающемуся плоду.
Этиология возникновения и пути заражения
Как передается молочница? В подавляющем большинстве клинических картин происходит заражение изнутри. Известно, что грибки Кандида присутствуют в организме каждого человека, предстают условно-патогенной микрофлорой.
Иными словами, грибок есть у женщин, мужчин и маленьких детей, но в незначительном количестве. Его размножение регулируется деятельности иммунной системы. Если наблюдается сбой, то активизируются патогенные грибки.
Описание грибка рода Сandida
Новорожденному грибок может передаться во время родов, если у мамы в анамнезе урогенитальный кандидоз. Основные пути передачи среди взрослого населения – незащищенный половой акт с носителем грибка.
Причины проявления инфекции в организме:
- Сильный стресс, нервное напряжение, эмоциональное потрясение;
- Заболевания, негативно влияющие на состояние иммунного статуса. Например, анемия приводит к снижению иммунитета, особенно у мужчин;
- Дефицит витаминов и минеральных веществ в организме;
- Длительное нахождение под ультрафиолетовыми лучами;
- Антибактериальная терапия в течение долгого времени приводит к размножению грибков Кандида;
- Расстройство обменных процессов, избыточный вес. Вследствие ожирения под кожей возникает жировая прослойка, являющаяся благоприятной средой для размножения грибка, так как в ней тепло и влажно.
Нередки проявления кандидоза у мужчин и женщин, страдающих сахарным диабетом. Патология хронического характера приводит к повышенному потоотделению, как результат, увеличивается влажность кожного покрова, создается благоприятная среда для размножения грибков Кандида.
Важно: спровоцировать развитие молочницы может ношение белья из синтетической ткани, использование средств гигиены с большим содержанием химических веществ.
Диагностика
При обнаружении первого симптома кандидоза следует обратиться к врачу для выяснения диагноза. Диагностика кандидоза включает в себя:
- Общий осмотр пациента и места активизации недуга.
- Взятие мазка с пениса и участков кожи, которые характеризуются проявлением недуга.
- Микроскопическое обследование окрашенного и не окрашенного мазков.
- Полный комплекс обследования пациента.
Взятие анализов из мочеиспускательного канала производится в утренний период до мочеиспускания. Мазок с плоти берётся в любое время, но только не после проведения гигиенической процедуры.
Обязательно следует также провериться не только мужчине с симптомами кандидоза, но и его половой партнёрше, чтобы исключить вероятность повторного заражения. После установления диагноза потребуется соответствующее лечение, каким оно должно быть, описано ниже.
Причины
В большинстве случаев процесс развития кандидоза запускается при ослаблении как местного, так и общего иммунитета после перенесенных инфекций или при заболеваниях хронического характера.
Кроме того, молочница появляется под воздействием следующих факторов:
- Гормональный дисбаланс.
- Прием комбинированных оральных контрацептивов.
- Дисбактериоз.
- Длительный прием кортикостероидов, цитостатиков и антибиотиков.
- Смена климатических условий.
- Использование средств, предназначенных для интимной гигиены. Как правило, они содержат большое количество ароматизаторов и щелочи.
- Регулярное использование ежедневных прокладок.
- Ношение неудобного и узкого нижнего белья, а также изделий из синтетических материалов.
- Использование дезодорированных прокладок и тампонов.
- Несбалансированное питание. Росту грибка способствует употребление кондитерских изделий, острых и жирных блюд, газированных напитков, различных соусов.
- Авитаминоз.
- Избыточная масса тела.
- Нарушение обменных процессов.
- Курение.
- Длительное пребывание в состоянии стресса.
Под воздействием одного или нескольких вышеперечисленных факторов происходит уменьшение количества полезных бактерий, выделяющих молочную кислоту. В результате рН влагалища сдвигается в щелочную сторону, что является благоприятным фактором для размножения грибка.
Какие факторы провоцируют быстрое развитие заболевания
- Сильный стресс.
- Простудные и вирусные заболевания в остром периоде.
- Хронические заболевания, такие как диабет, заболевание печени и желчного пузыря, ожирение, заболевания легких, тонзиллит, бронхит.
- Частая смена половых партнеров.
- Курение, алкоголизм.
- Не соблюдение правил гигиены.
Если мужчина болен молочницей, то он может заразить женщину
Конечно это не все факторы, которые могут привести к быстрому развитию заболевания, но основные моменты необходимо запомнить особенно мужчинам, потому что именно мужчины значительно меньше обращают внимание на незначительные симптомы болезни и вовремя не обращаются за медицинской помощью. Являясь носителем заболевания, мужчина не обращается к врачу, даже если у его партнерши это болезнь диагностирована, забывая или не зная о том, что лечить необходимо обоих партнеров.
Женщины более подвержены заболеванию молочницей, раньше считалось, что только она и может быть переносчиком болезни, особенно для своего новорожденного ребенка. Но последние данные говорят о том, что и мужчина не менее склонен к этому заболеванию, иногда с более тяжелыми последствиями, именно потому, что молочница не проявляется у них так остро как у детей или у женщин.
Через сколько проявляется кандидоз у мужчин
Немногие знают, через сколько дней проявляется молочница после заражения. Чтобы ответить на данный вопрос, следует изучить особенности протекания болезни и причины ее возникновения.
Вне зависимости от того, каким является заболевание, оно имеет несколько периодов развития. Как правило, заболевания протекают в следующих формах:
Если говорить конкретно о молочнице, то от момента заражения до появления первых симптомов иногда проходит несколько часов, дней и даже месяцев. Чаще всего зараженный человек не сразу узнает о наличии заболевания. Грибок обычно распространяется по организму и спустя некоторое время начинает проявляться.
Внутри у человека присутствует огромное количество различных бактерий, вирусов, микроорганизмов. В силу определенных причин они могут активно размножаться. Так происходит и с грибком рода Candida.
В период размножения он может быть опасен для здоровья человека.
У взрослых людей и детей молочницей часто поражаются:
- половые органы;
- ротовая полость;
- кожный покров.
Нередко кандидоз развивается у ребенка сразу после его рождения. Это объясняется тем, что беременная женщина являлась переносчиком инфекции.
Помните, что если не соблюдать правила гигиены, то это будет способствовать развитию кандидоза. Данный факт касается как детей, так и взрослых людей. Если вас интересует, через какое время проявляется молочница, то учитывайте, что у мужчин и женщин болезнь развивается по-разному. Кандидоз внешне можно определить спустя 2–4 дня после заражения. Иногда инкубационный период молочницы у мужчин длится в течение целого месяца.
Через сколько дней проявляется молочница после заражения у женщин? В данном случае инкубационный период кандидоза длится 1–5 суток. Также симптомы могут возникнуть и через 15–20 дней. У детей кандидоз проявляется спустя 1–8 суток после заражения.
Если инфекция распространилась, то человек ощущает некоторый дискомфорт во время мочеиспускания. После инфицирования неприятные ощущения иногда возникают в процессе полового акта. Нередко люди присваивают обнаруженные симптомы к обычной простуде. Это может привести к обострению заболевания, которое вылечить будет очень сложно.
Нередко молочница развивается из-за пережитого стресса. Иногда причиной возникновения болезни служит простуда или наличие какого-то вируса. Грибок может начать расти из-за отдельных хронических заболеваний. Часто недуг появляется у диабетиков, людей, страдающих заболеваниями печени, легких, желчного пузыря. Причинами развития болезни служит:
- наличие нарушений гормонального фона;
- ожирение;
- частая смена половых партнеров;
- курение;
- употребление алкоголя;
- лечение онкологии;
- снижение защитных функций организма;
- использование белья из синтетики;
- неправильное питание;
- переохлаждение.
Также, как было сказано выше, кандидоз может возникнуть из-за несоблюдения правил личной гигиены.
Перечисленные факторы являются основными. Зная их, вы сможете вовремя остановить развитие заболевания. Прислушиваться к своему организму рекомендуется в особенности мужчинам. Нередко они являются носителями инфекции. Молочница у мужчин развивается сравнительно медленно и не всегда удается ее обнаружить. По этой причине мужчины могут откладывать посещение врача даже в случае выявления кандидоза у партнерши. В данном случае курс лечения рекомендуется проходить не только женщине, но и мужчине.
В случае обнаружения кандидоза у мужчин или женщин следует сразу же приступать к лечению. Таким образом удастся исключить переход болезни в хроническую форму. Всем людям нужно взять на заметку следующие признаки проявления кандидоза:
- Спустя день или несколько суток после полового акта болезнь проявляется в форме болезненных ощущений во время мочеиспускания.
- Иногда симптомы проявляются в виде характерного жжения и зуда в области половых органов.
- Нередко наблюдаются характерные выделения белого цвета во влагалище.
- Во рту возможно появление язвочек с белым налетом.
- На кожном покрове нередко возникает сыпь.
Указанные симптомы будут говорить о том, что произошло инфицирование, которое спровоцировало развитие грибка в организме. Иными словами, скрытая форма болезни перешла в острую. Проявления молочницы часто схожи с теми, которые возникают по причине воспаления мочевого пузыря, придатков и яичников. Иногда зараженные люди страдают от ноющей боли в области спины. Часто такие симптомы указывают на возникновение остеохондроза, невралгии.
У женщин молочница часто появляется перед началом менструации. Кандидоз проявляется наличием зуда, боли в районе расположения яичников, обильных или, наоборот, скудных выделений. Имейте в виду, что молочница чаще всего возникает у женщин, страдающих аллергическими заболеваниями.
После прохождения курса лечения у женщины кандидоз может снова возникнуть. Это объясняется тем, что носителем заболевания является партнер. Пока пара совместно не пройдет курс лечения, от болезни избавиться не получится. После нового полового контакта придется снова начинать восстанавливать здоровье.
По материалам venerologia03.ru
Грибковые болезни, вызванные грибками кандида, относят к условно-патогенной флоре. Они обитают на всех слизистых — половых путях, во рту, в кишечнике. Развиться кандидозам у мужской половины реально только при особенных условиях, делающих возможным рост колоний грибов после заражения или ослабления иммунных сил.
Статистика утверждает, что возникновение молочницы у мужчин, с ее типичными и постоянными признаками, более редкое явление, чем у прекрасной половины. Строение женских гениталий способствует тому, что в вагине микроорганизмы развивается гораздо интенсивнее, а воспалительные явления возникают быстрее. Мужские же гениталии устроены так, что грибку расти здесь гораздо затруднительнее.
Так как у слабой половины это заболевание встречается намного чаще и имеет более мягкие проявления или, вообще, протекает без них, то при регулярных сексуальных связях с женщиной с хронической молочницей, мужчина нередко инфицируется.
А будет ли прогрессировать у него молочница с присущей ей симптоматикой и осложнениями — связано с иммунным ответом его организма и присутствия определенных провоцирующих обстоятельств.
Все признаки мужского кандидоза рассматриваются как иммунные нарушения, состояние иммунодефицита организма в общем. Даже если здоровый мужчина с сильной иммунной системой и инфицируется, он самоизлечивается или быстро выздоравливает после противомикозной терапии. Осложнения могут развиваться и переходить в хроническую форму молочницы при ослабленным иммунитете у мужчин. Он должен находиться под постоянным наблюдением у врача-дерматолога, а если появились осложнения, может потребоваться лечение в условиях стационара.
Какие же факторы предрасполагают к развитию мужского кандидоза? Основные из них:
- Продолжительное нахождение в состоянии стресса;
- Эндокринные нарушения — сахарный диабет, гипофункция щитовидной железы. Такие патологии часто сопровождаются повышенной влажностью кожи, что приводит к быстрому росту грибковой флоры;
- Патологии крови, анемичные состояния, онкология, при лечении которой снижается иммунитет;
- Гиповитаминоз, недостаток микроэлементов;
- Продолжительное нахождение под воздействием низких температур;
- Антибиотикотерапия, продолжительное их применение, терапия кортикостероидами;
- Инсоляции, слишком сильный загар приравнивают к небольшим дозировкам вредного, не приносящего пользы облучения;
- Повышенный вес: при большом количестве подкожного жира Кандида делятся быстрее, поскольку при таких обстоятельствах создаются наиболее благоприятные условия для их размножения.
У десяти-пятнадцати процентов мужчин симптомы молочницы не имеют никакого проявления. Если она все же проявится, то совершенно не так, как у женской половины общества. Молочница у сильной половины может проявляться, кроме гениталий, во рту, на коже. Если у мужчины наблюдается кандидозная инфекция — стоматит или кожные поражения, это всегда является подтверждением иммунодефицита, как первичного, так и вторичного.
Как проявляется молочница у мужчин? Эти проявления сходны между собой. Симптомы кандидоза у мужчин таковы:
- Наружные гениталии выглядят отечными, воспаленными, гиперемированными (можно увидеть на фото);
- Эрекция вызывает боль, во время секса также может возникать болезненность;
- Ощущается жжение и боль, когда пациент мочится;
- Зудит уретра — периодически или постоянно;
- Бело-сероватый налет с кислым запахом.
Грибковая патология у сильной половины нередко сочетается с другими недугами инфекционного происхождения, которые передаются при сексуальных контактах, в скрытом состоянии. Через какое время проявляется молочница у мужчин с момента попадания возбудителя в организм? Определенных сроков у этой патологии в отношении мужского организма нет. Она может не дать о себе знать никогда, а может — и сразу после заражения. Поэтому вопрос о том, через сколько дней проявится мужской кандидоз, нельзя считать корректным.
Кандидозные воспалительные процессы в области головки пениса — баланиты, крайней плоти — поститы, а когда они совмещаются — баланопоститы, могут быть вызвано как только кандидами, так и в виде сочетанной патологии с другими половыми инфекциями — уреаплазмой, трихомонозом, гонореей, герпесом генитальным, хламидиями.
При кандидозном баланопостите появляется на головке члена кашицеподобный беловато-серый налет, если удалить его, можно увидеть кровоточащую эрозию. Может наблюдаться отек гениталий, зловонный запах, напоминающий прокисшее молоко. Пенис гиперемирован, больной жалуется на нестерпимый зуд. Можно эти признаки увидеть на фото.
Кандидозный уретрит может себя проявить как свежая гонорея. Кроме отека, зуда, гиперемии, наблюдается учащение позывов к мочеиспусканию. Сам процесс мочеиспускания болезнен, моча с мутью и кровяными примесями или обильными слизистыми выделениями. Каждый день по утрам можно заметить белые нитеобразные выделения.
Грибковый пиелоцистит является осложнением кандидоза. Он возникает, когда кандидозное воспаление поднимается вверх по мочевыделительным путям. Страдают простата, мочевой пузырь, почки. При этом человек отмечает ухудшение самочувствия, лихорадку, болезненность при коитусе и мочеиспускании, наблюдающаяся не только в уретре и наружных гениталиях, но и мочевом пузыре и почках .
Пиелоцистит кандидозного происхождения может сочетаться с другими инфекционными процессами — эшерихией коли, гонококком, энтеробактером, протеями, хламидиями и др.
Как же лечится молочница у мужчин? Все лечебные мероприятия следует проводить после подтверждения лабораторными тестами. Только основываясь на характерных симптомах мужского кандидоза невозможно установить диагноз. Не стоит заниматься лечением самостоятельно, часто могут проявляться и другие, находящиеся в дремлющем состоянии скрытые инфекции половых путей.
Мало того, если мужчина имеет половые контакты с женщиной, с которой у него постоянные отношения, и во время секса с нею он не пользуется презервативами, то придется обследоваться и ей. После этого проводят совместную противогрибковую терапию обоих.
Если в исследованиях определяется одна молочница у мужчины, то лечение может проводиться местно (в виде противокандидозных мазей), также применяют системные таблетированные средства борьбы с грибком. Это зависит от того, насколько выражены проявления молочницы у представителя сильной половины, признаков и запущенности патологического процесса.
Если после терапевтических процедур молочница опять начинает беспокоить, значит, у мужчины по каким-то причинам ослабился иммунитет или его сексуальные партнерши больны кандидозом. Назначается повторный курс лечебных мероприятий. С мужчиной проводят беседу о том, что ему нужно исключить любые половые контакты без презервативов.
При хроническом кандидозном воспалении, при слабой реакции иммунной системы на патогенную флору, при регулярном приеме антимикотиков, грибки быстро становятся устойчивыми и в этом случае лечение может стать бессильными.
При постоянно повторяющемся грибковом воспалении, невозможным становится удаление грибков только путем медикаментозной терапии. Важно избегать любых незащищенных связей, важно изменить питание и весь образ жизни, быть подвижным, исключить вредные привычки, серьезно отнестись к укреплению иммунной системы.
Кроме использования разных лекарств применяемых наружно, здорового питания и образа жизни в целом, важно также соблюдение правил личной гигиены. Важен корректный уход за телом и половыми органами. Перед началом терапии молочницы, нужно сменить белье или можно прокипятить то, которое есть. Носить нужно свободное и натуральное белье.
Наиболее мудрым решением будет не жить половой жизнью во время противогрибкового лечения, особенно, если она беспорядочная. Нельзя купаться в ванной, только под душем. Во время гигиены за наружными гениталиями нельзя использовать средства для тела, после приема душа нужно вытереть половые органы насухо при помощи чистого индивидуального полотенца.
По материалам stojak.ru
Такое грибковое заболевание, как
молочница, или в медицине кандидоз, — достаточно частая инфекция. Зачастую недуг поражает женщин, но бывают случаи, когда заболевают мужчины, а в довольно редких случаях и дети. Грибки типа Candida можно найти в организме любого человека, однако заболевание может проявиться лишь под влиянием некоторых причин, которые ослабляют защитные функции. Во время инкубационного периода молочницы происходят изменения в организме, при которых инфекция укрепляется в микрофлоре инфицированного.
Инфицированный человек может и не знать о наличии болезни, пока не появятся первые симптомы. Через сколько проявляется молочница после заражения? Латентный срок формирования кандидоза обусловлен некоторыми факторами и колеблется от двух суток до двух месяцев. Причем у отдельной категории людей с устойчивой иммунной системой.
Для того чтобы понимать, как появляется молочница, необходимо разобраться в ее природе и возможностях попадания в организм.
- Грибы типа Candida нужны человеческому организму, чтобы как положено функционировала микрофлора имеющихся слизистых, кожных покровов и внешних слоев внутренних органов. Однако под воздействием некоторых факторов болезнетворные штаммы способны к быстрому делению.
- Заражение может произойти во время полового акта, если сексуальный партнер инфицирован. Причем зачастую мужчины являются носителями болезнетворного грибка.
- Причиной может стать ослабленная иммунная система, длительный прием антибиотиков либо медикаментозных средств, которые назначаются для врачевания мочеполовых органов.
- Причинами инфицирования женщин могут стать изменения в гормональном фоне, которые происходят при беременности либо менструальном цикле.
- Если человек употребляет в пищу продукты, содержащие большое количество глюкозы, также может развиться молочница. Поскольку глюкоза благоприятствует ее развитию.
Однако симптоматика у представительниц женского пола более выражена, в отличие от мужчин. Это является причиной того, что зачастую женщина считается носительницей инфекции.
Через сколько дней проявляется молочница после заражения? Это происходит у каждого инфицированного специфически и обусловлено формой болезни:
- В большинстве случаев скрытое формирование недуга при латентной молочнице – 3-5 суток. Однако, когда заболевание осложнено вульвовагинитом (воспалением тканей влагалища) проявление симптоматики может затянуться до 14 дней.
- Проявление заболевания может проявиться спустя пару недель, а иногда и 2 месяца. Это происходит, когда молочнице сопутствует кандидозный уретрит, то есть поражены мочевыводящие каналы. Такой тип болезни способен поразить мочевой пузырь и почки.
- Если проявляется молочница у мужчин, то инкубационный период составляет от пяти суток до 2-х месяцев.
- В отдельных ситуациях можно параллельно заразиться иными болезнями как обычными инфекционными недугами, которые передаются при сексуальном контакте, так и венерологическими.
Зачастую первые ощущения наличия грибкового заболевания у зараженного появляются спустя 7 дней с момента занесения инфекции в организм, в отдельных случаях это может продлиться до двух месяцев. Такой интервал обусловлен некоторыми причинами, в том числе и привычками, относящимися к правилам личной гигиены, а также состоянием иммунной системы.
Так на какой день после заражения
проявляется молочница у представительниц прекрасной половины человечества? Если у женщины вагинальный кандидоз, то симптоматика проявляется уже на второй либо пятый день. Признаки способны быстро усиливаться и нарастать. К окончанию третьих суток могут проявиться такие симптомы, как отек половых губ, раздражение, влагалищные выделения, похожие по консистенции на творог.
Грибковую инфекцию с легкостью можно занести во время сексуального контакта с инфицированным партнером. Самый опасный момент – это, когда выделения из влагалища похожи на свернутое молоко.
При преобразовании заболевания в хроническую форму признаки кандидоза будут проявляться с периодичностью. Зачастую грибок активизируется перед началом менструации, а по окончании признаки пропадают. Кандидоз обостряется при овуляциях, в остальное время менструального цикла болезнь никак себя не проявляет.
Основная логика формирования кандидоза:
- От 20 до 60 суток – развивается кандидозный уретрит;
- От 2 до 14 суток – формирование кандидозного баланита;
- От 2 до 14 суток – происходит проявление вульвовагинита.
Молочница в инкубационный период символизируется прохождением трех-четырех стадий своего невидимого течения.
Первый этап – проникновение. Осуществляется инфицирование в момент перехода грибка между половыми партнерами (от инфицированной женщины к мужчине либо в обратном направлении) либо с одного инфицированного участка на другой (к примеру, когда у малыша в ротовой полости есть молочница, а он берет материнскую грудь). Закрепление болезнетворного микроорганизма происходит лишь в подходящей для его развития среде. А именно, в организме со слабой иммунной системой либо во время болезни или перемены в гормональном фоне. В том случае, когда грибок типа Candida не встречает противодействия со стороны организма (лимфоцитов, иммуноглобулинов, тех же микроорганизмов-антагонистов), то формируется второй этап заболевания.
Второй этап – размножение.
Болезнетворный грибок быстро увеличивает свой объем, иногда остается на внешних слоях слизистых оболочек и дожидается перемены кислотно-щелочного баланса либо снижения защиты инфицированного организма. Происходит проявление видимых симптомов кандидоза. В случае, когда развитию инфекции ничего не препятствует, происходит поражение оболочек ткани и переход заболевания на другую ступень формирования.
Третий этап – попадание в слои и прогрессирование. Грибок проникает в слой ткани глубже (на 5-7 мм). Признаки недуга начинают прогрессировать. Если к этому моменту не начать врачевание, то заболевание преобразуется в запущенную форму. Лечение такой формы болезни будет достаточно сложным, и понадобится много сил и времени.
Четвертый этап – попадание в кровь. Болезнетворные грибки поражают организм, попадая в него через кровеносную систему, происходит инфицирование внутренних органов. Заболевание может распространиться на почки и легкие. Кроме того, у мужчин возможно обострение воспалительных процессов в простате, а у беременных женщин нанесение вреда развивающемуся плоду. В случае глобального инфицирования внутренних органов возможно наступление летального исхода.
Характерная особенность организма мужчины заключается в следующем – инфицирование представителя сильной половины человечества не становится следствием слабой иммунной системы, нехватки витаминов в организме, дисбактериоза, что зачастую становится причиной заболевания у женщин. Заболевание у мужчин чаще всего проявляется на фоне хронических заболеваний таких, как СПИД, сахарный диабет, туберкулез. Кроме того, немаловажный фактор – присутствие у сексуальной партнерши венерологических болезней. Первичные симптомы отмечаются сразу же после сексуального контакта, однако они пропадают очень скоро без даже какого-то лечения.
У мужчин, зараженных кандидозом, инкубационный период может занять около пяти суток. В это время представитель мужского пола замечает первые симптомы заболевания:
- Зуд и жжение;
- Наслоения на головке белесоватого цвета;
- На головке появляется краснота.
Чувство боли проявляется по окончании полового акта с инфицированной партнершей. Иногда мужчины ощущают неудобство при самом акте, в то время как по окончании неприятные ощущения пропадают.
Когда же инфицирование осуществилось, то следует прекратить на время сексуальные контакты. Это связано с тем, что при воздействии на головку полового члена при половом контакте слой Candida отрывается. Это может стать причиной того, что воспаленный кожный покров начнет кровоточить. При дальнейшем механическом воздействии на воспаленные слизистые на головке и крайней плоти могут увеличиться микроскопические повреждения, что повышает возможность воспалительных процессов и образования язв.
Симптомы проявления молочницы у представителей мужского пола, кроме налета либо хлопьев белого цвета вокруг головки, следующие:
- Болезненный процесс мочеиспускания;
- Раздражение;
- Выделения в виде ниточек.
Этим обусловлено легкое инфицирование полового органа мужчины: воспаление крайней плоти и головки, отечность полового органа. Без врачевания головка может покрыться трещинками и эрозиями.
В случае формирования воспаления полового члена по причине молочницы, можно сказать, что вы неправильно соблюдаете правила личной гигиены.
Кроме того, в отдельных случаях
мужчины заболевают при длительном приеме антибиотиков. Нарушенный баланс микроорганизмов становится причиной того, что грибок размножается.
Зачастую кандидоз проявляется у мужчин в достаточно юном возрасте. Причиной являются беспорядочные половые связи без применения защитных средств, а также активное изменение гормонального фона в организме. Благодаря этому, молодежь относят к группе риска.
Для получения более эффективного результата от лечения кандидоза следует изначально выяснить причину инфицирования. В том случае, когда больна беременная женщина, то врачевание в обязательном порядке должно проводиться и у мужа.
Если причина заболевания кроется в ослабленной иммунной системе, то кроме медикаментозных препаратов, необходимых для лечения молочницы, следует пройти курс приема иммуномодуляторов.
Если причиной заболевания стал дисбактериоз, то необходимо начать прием пробиотиков.
Если снижено защитное функционирование мужского и женского организма из-за недостатка витаминов, то необходимо пройти курсовой прием витаминных препаратов. Это даст возможность укрепить иммунную систему и избежать повторения болезни.
Лечение молочницы и полнейшее пропадание признаков может занять различное количество времени. В среднем лечение до полного выздоровления занимает около 10 суток. Если болезнь перешла в тяжелую форму, то срок излечения будет продлен.
Лечение кандидоза должно проводиться у обоих партнеров даже в случае, когда явные симптомы проявились лишь у одного. Длительность лечения, которое понадобится для обоих, определяет специалист.
В случае выраженных симптомов кандидоза женщина обязана обратиться в женскую консультацию и пройти осмотр у гинеколога, ведь ее поведением обусловлено и состояние здоровья партнера.
Мужчина должен пропить
курс медикаментозных препаратов для профилактики. Когда же симптомы все-таки проявились, то следует проконсультироваться у терапевта либо андролога.
Кроме этого, чтобы подавить грибок следует соблюсти некоторые правила:
- Откажитесь от приема в пищу сладких десертов и белого хлеба;
- Добавьте в рацион питания молочнокислую продукцию;
- Исключите из рациона йогурт;
- Старайтесь как можно больше проводить времени на свежем воздухе;
- Постарайтесь избегать попадания в стрессовые ситуации.
На какой день проявляется молочница, зависит от состояния иммунной системы инфицированного. Поэтому при проявлении первых симптомов посетите врача, чтобы вовремя начать лечение.
По материалам gribokube.ru
Как излечить молочницу
Для получения более эффективного результата от лечения кандидоза следует изначально выяснить причину инфицирования. В том случае, когда больна беременная женщина, то врачевание в обязательном порядке должно проводиться и у мужа.
Если причина заболевания кроется в ослабленной иммунной системе, то кроме медикаментозных препаратов, необходимых для лечения молочницы, следует пройти курс приема иммуномодуляторов.
Если причиной заболевания стал дисбактериоз, то необходимо начать прием пробиотиков.
Если снижено защитное функционирование мужского и женского организма из-за недостатка витаминов, то необходимо пройти курсовой прием витаминных препаратов. Это даст возможность укрепить иммунную систему и избежать повторения болезни.
Лечение молочницы и полнейшее пропадание признаков может занять различное количество времени. В среднем лечение до полного выздоровления занимает около 10 суток. Если болезнь перешла в тяжелую форму, то срок излечения будет продлен.
Лечение кандидоза должно проводиться у обоих партнеров даже в случае, когда явные симптомы проявились лишь у одного. Длительность лечения, которое понадобится для обоих, определяет специалист.
В случае выраженных симптомов кандидоза женщина обязана обратиться в женскую консультацию и пройти осмотр у гинеколога, ведь ее поведением обусловлено и состояние здоровья партнера.
Мужчина должен пропить
курс медикаментозных препаратов для профилактики. Когда же симптомы все-таки проявились, то следует проконсультироваться у терапевта либо андролога.
Кроме этого, чтобы подавить грибок следует соблюсти некоторые правила:
- Откажитесь от приема в пищу сладких десертов и белого хлеба;
- Добавьте в рацион питания молочнокислую продукцию;
- Исключите из рациона йогурт;
- Старайтесь как можно больше проводить времени на свежем воздухе;
- Постарайтесь избегать попадания в стрессовые ситуации.
Общие рекомендации по лечению и профилактике молочницы
Столкнувшись с такой неприятной болезнью, как молочница, женщине, прежде всего, нужно понимать, что это грибы, которые паразитируют на её слизистых. Если лишить их питательной среды, они погибнут. Грибы рода Кандида любят сладкую среду и питаются плесневыми дрожжами. Значит нужно ограничить употребление сладостей и продуктов, содержащих дрожжи. А взамен стоит увеличить в рационе долю кисломолочных продуктов. Для успешной борьбы с заболеванием нужно выяснить, что его спровоцировало и устранить причину. Существуют медицинские препараты, которые разрушают грибок и нарушают его способность прикрепляться к слизистым.
Чтобы снять воспаление слизистых, можно использовать травяные ванны и спринцевания ромашкой. Для интимной гигиены стоит выбирать мягкие средства, предназначенные специально для этих целей. Некоторые из них включают в свой состав пробиотики, которые восстанавливают микрофлору половых органов, мягко очищают и снимают зуд. Так же нужно вести здоровый образ жизни, беречь себя от инфекционных болезней, которые подрывают иммунитет, избегать стрессов.
На развитие патологической флоры на половых органах влияет также качество нижнего белья, которое непосредственно контактирует со слизистыми. Ведь синтетические ткани плохо пропускают воздух, плохо впитывают выделения и это способствует размножению грибков и бактерий. Бельё нужно выбирать из натуральных тканей, оно не должно давить и натирать. И самое важное: чтобы не упустить начало молочницы в её инкубационный период, не пропускайте плановые приёмы врача гинеколога.
Механизм развития
В норме во влагалище кислый рН среды. За счет этого патогены, попавшие в организм, погибают. Другими словами, рН — это своеобразный барьер, который препятствует размножению грибков и распространению прочей инфекции. Под воздействием различных неблагоприятных факторов степень защиты ослабевает, то есть нарушается естественная среда.
Возбудителем молочницы является патоген рода Candida. Попадая в организм, он поражает слизистые оболочки. Грибок питается глюкозой. Активная его жизнедеятельность способствует уменьшению количества полезных бактерий. Инкубация молочницы — это кратковременный период. При отсутствии лечения патоген очень быстро распространяется на другие внутренние органы.
Диагностика молочницы в инкубационный период
Обнаружить молочницу в инкубационном периоде, когда она никак себя не проявляет, можно на плановом приёме у гинеколога. Врач всегда берет мазок на анализ слизи, в которой и обнаруживается увеличенное количество грибка. Когда в мазке обнаружена инфекция, её тестируют на восприимчивость к антибиотикам, и врач, основываясь на результатах, приписывает соответствующее лечение.
Если заболевание обнаружено в инкубационный период, оно довольно легко лечится. Достаточно единоразового приёма внутрь противогрибкового препарата, или местного воздействия лекарственными средствами от грибка, в форме свечей, мазей, лосьонов. Важно так же одновременно с лечением женщины от кандидоза пролечить и партнера, чтоб они не заражали друг друга повторно.